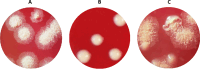

Infection model of THP-1 cells, growth dynamics, and antimicrobial susceptibility of clinical Mycobacterium abscessus isolates from cystic fibrosis patients: Results from a multicentre study
- PMID: 40163512
- PMCID: PMC11957364
- DOI: 10.1371/journal.pone.0319710
Infection model of THP-1 cells, growth dynamics, and antimicrobial susceptibility of clinical Mycobacterium abscessus isolates from cystic fibrosis patients: Results from a multicentre study
Abstract
Mycobacterium abscessus (MABS) is an emerging pathogen causing severe infections, particularly in cystic fibrosis (CF) patients. A prospective multicentre study included CF patients from four hospitals in Madrid between January 2022 and January 2024. Respiratory samples were collected, and MABS isolates were analysed to determine their antibiotic resistance profiles, growth dynamics, infection kinetics, intracellular behaviour, and pathogenicity. Intracellular bacterial growth and macrophage viability were evaluated through THP-1 cell infection experiments, with and without amikacin. Phenotypic susceptibility testing and genotypic susceptibility testing were also conducted. Among 148 patients, 28 MABS isolates were detected from 16 patients (10.8%), and the first isolate from each patient was analysed. Isolation was more prevalent in younger individuals (median age 24.4 vs. 28.4 years, p = 0.049), and most isolates (81.25%) were identified as M. abscessus subsp. abscessus (MABSa). MABS isolates exhibited high resistance rates (>85%) to doxycycline, tobramycin, ciprofloxacin, moxifloxacin (75%) and cotrimoxazole (56.3%). Amikacin resistance (18.8%) was higher than expected, and inducible (10/16 isolates) or acquired (1/16 isolate) macrolide resistance was found in 68.8% of strains. Phenotypic and genotypic testing results were fully concordant. Tigecycline demonstrated strong in vitro activity, and resistance to imipenem, linezolid, and cefoxitin remained low. Rough strains displayed lower optical density values in later growth stages, probably due to their increased aggregation. In THP-1 cell infection experiments, rough strains showed higher intracellular bacterial loads with statistically significant differences observed at 2 hours (both with and without amikacin) and at 72 hours (with amikacin) post infection. Notably, rough strains also exhibited a higher internalisation index and greater impact on THP-1 cell viability, especially in the absence of amikacin.
Copyright: © 2025 Ruedas-López et al. This is an open access article distributed under the terms of the Creative Commons Attribution License, which permits unrestricted use, distribution, and reproduction in any medium, provided the original author and source are credited.
Conflict of interest statement
The authors have declared that no competing interests exist.
Figures

References
Publication types
MeSH terms
Substances
Grants and funding
LinkOut - more resources
Full Text Sources
Medical
Molecular Biology Databases

